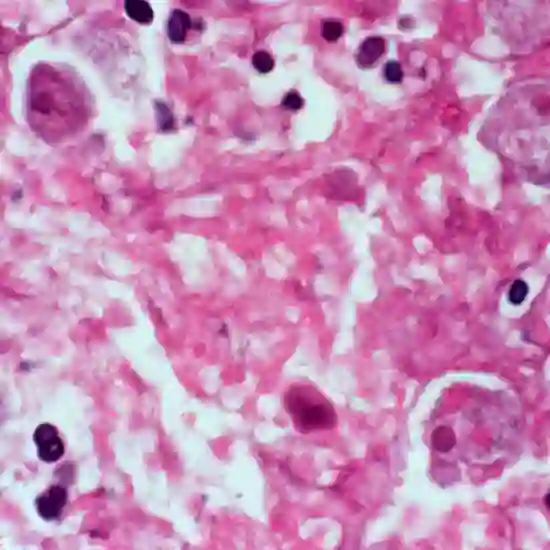

Book Amoebic Serology Appointment Online Near me at the best price in Delhi/NCR from Ganesh Diagnostic. NABL & NABH Accredited Diagnostic centre and Pathology lab in Delhi offering a wide range of Radiology & Pathology tests. Get Free Ambulance & Free Home Sample collection. 24X7 Hour Open. Call Now at 011-47-444-444 to Book your Amoebic Serology at 50% Discount.
Amoebiasis is a parasitic infection. It is caused by amoebae, Entamoeba histolytica in the colon. Amoebic Serology is a serum test. It is used to differentiate liver cysts and pancreatic infections from amoebic dysentery. The test is recommended by doctors to detect an existing or past infection and if the patient has the symptoms such as belly cramps, weight loss, bloody diarrhoea, ulcerative colitis, stomach ache etc.
No special preparation is required.
A blood sample is collected from the vein in the arm of the patient for the amoebic serology test.
The cost of Amoebic serology near me in Delhi ranges from INR 1000 to INR 1500.
| Test Type | Amoebic Serology |
| Includes | Amoebic Serology (ELISA) - lab tests |
| Preparation | No special preparation is required. |
| Reporting | Within 24 Hrs* |
| Test Price |
₹ 1080
|

Early check ups are always better than delayed ones. Safety, precaution & care is depicted from the several health checkups. Here, we present simple & comprehensive health packages for any kind of testing to ensure the early prescribed treatment to safeguard your health.